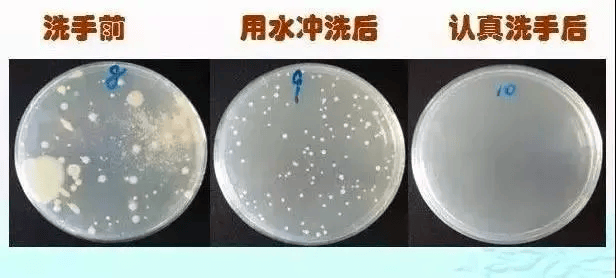

你家的洗手液,可能已变成“毒液”
谁懂啊家人们
看到这样抽象的东西
居!然!想!买!
图源:小红书用户“嘻了个瓜”
为了给洗手增添一点乐趣
也是拼了
但是吧,洗手这件小事
不洗,那肯定是没效
洗了,也不一定就有效
洗不对,还可能有反作用
洗手液一不小心变成“毒液”
这到底是咋回事?
01
不是所有的洗手液
都能杀菌
为啥强调上完厕所后要洗手?还不是因为怕手上沾满细菌。如果用沾满细菌的手,再去摸手机、摸脸,很容易就将细菌送入嘴中,不知不觉就染上小毛病了。
图源:科普中国
而目前市面上售卖的洗手液,并不是所有的都能杀菌。
✎ 日常生活中:
常规的洗手液就能够满足清洁功能,它以表面活性剂为主要成分,通过泡沫带走污垢和部分微生物,不具备持续杀菌或抑菌功能。用常规洗手液配合流动水冲洗,就能达到卫生标准。

✎ 而在医院、接触公共设施(如公厕扶手、地铁扶手)、照顾病人或疫情高发期等场景中:
手部可能沾染致病菌,这就需要通过抑菌/抗菌型洗手液来降低感染风险。
一般可选用的有:
特种洗手液:在常规洗手液基础上,添加了抑菌或抗菌成分,能有效抑制或杀灭金黄色葡萄球菌、大肠埃希菌等常见致病菌。
免洗洗手液:通过酒精等消毒成分清除手部致病菌的同时,溶剂会自动挥发,无需水洗即可完成手部清洁、抗菌或抑菌。但要注意的是,它对于艰难梭菌、诺如病毒等抵抗力较强的病原体杀菌作用有限,不能完全替代“流动水+洗手液”的清洗方式。
一个方法教你判断:
常规洗手液标注“妆字号”;
抑菌/抗菌型洗手液标注“卫消证字”。

图源:自己拍的
02
洗手液变“脏了”
千万别用!
万一洗手液过期或者变质,就可能滋生细菌,不仅没起到清洁的作用,反而可能有反作用——洗手液变“毒液”!
使用被病原菌污染的洗手液,会沾染大量病原体,越洗越脏,容易引发感染。
洗手液还能不能用?这3个细节能帮你初步判断:
① 看:液体是否浑浊、分层、有絮状物或沉淀。
② 闻:是否产生酸腐、霉味或异常刺鼻气味。
③ 触:粘稠度是否异常,使用后皮肤是否出现发痒、刺痛等感觉。
如出现以上情况,应立即停用。


图源:小红书用户“杏仁巧克力”
03
洗手液用完了
千万别做这件事!
是谁用完洗手液还能兑水再用俩星期?劝你趁早收手!
用洗手液最好坚持这两个原则:
选原装瓶;
用完即弃。
如果要进行分装,最好注意这两点:
① 切勿将新洗手液直接倒入旧液中,应先清洗再灌装;
② 选择易清洁容器:优先选用广口瓶或可拆卸泵头设计,便于深度清洁。
不然就别费那功夫了,因为潮湿的环境极易成为病原菌繁殖的温床,小心吃力不讨好。

图源:小红书用户“odokei”
04
出门在外
如何放心洗手?
✎ 最简单也是最放心的:
用流动水+洗手液洗手,遵循“七步洗手法”,揉搓不少于20秒,彻底冲洗干净。


图源:soogif
✎ 最便捷的:
可携带酒精含量60%-80%的免洗洗手液或消毒湿巾,在无法接触流动水时使用。
✎ 可能没那么卫生的:
谨慎使用公共场所的洗手液和烘干机。有调查显示,部分机场、公厕洗手液细菌超标达600倍;烘干机更可能将冲厕飞溅的细菌吹至全身。


图源:水印

来源 | 深圳疾控
初审 | 石芮
复审 | 郭亮永
终审丨肖鸿广
统筹 | 健康教育与促进科
【免责声明:我们尊重原创、注重分享,图文资料仅用于科普公益宣传,版权归原作者所有,如有侵犯您的权益请及时私信后台或公众号留言,我们将在48小时内删除】
健康南宁 疾控先行
地 址:南宁市兴宁区厢竹大道55号
【 咨询电话 】
咨询电话时间:
每周一至周五(法定节假日除外)
上午8: 00-12:00
下午15:00-18:00
疫苗接种及犬伤暴露伤口处理:
周一至周五:上午8:00-11:30 ,下午14:30-21:00
周末、节假日:上午8:00-11:30,下午14:30-17:00
(疫苗接种后需要留观30分钟,请您提前30分钟前来就诊)
健康证体检时间:每周一至周五(法定节假日除外)
上午8:00-11:30,下午14:30-17:00
健康证领证时间:每周一至周五(法定节假日除外)
上午8:00-12:00,下午14:30-17:30
皮肤诊疗业务:周一至周五(法定节假日除外)
上午 8:00-12:00, 下午14:30-17:30
